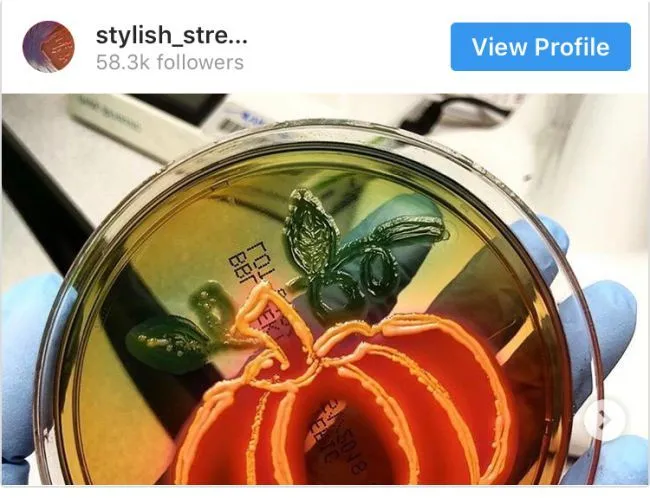

รวม 20 ภาพน่าทึ่ง ที่เกิดขึ้นและถูกบันทึกภาพได้ทันเวลา
ในโลกของเรานี้ช่างหมุนไปอย่างรวดเร็วใบนี้ มีอะไรที่่แปลกใหม่และน่าเหลือเชื่อชวนให้รู้สึกอัศจรรย์ใจอยู่มากมาย และบางอย่างก็เกิดขึ้นจากผลงานทางธรรมชาติที่ร้อยเรียงมาให้พวกเราได้สัมผัสกับความน่าทึงของโลกอยู่เสมอ
เหมือนกับภาพที่คุณจะไปชมต่อไปนี้ คือตัวอย่างความไม่ธรรมดา ที่บอกเลยว่าบางอย่างก็เจ๋งสุดๆ บางอย่างก็ชวนให้แปลกใจ
1 ตะกอนจากปฏิกิริยาเคมีหลอดนี้ ออกมาดูเหมือนกับป่าดงดิบ
2 Amorphophallus Titanum เป็นหนึ่งในดอกไม้ที่ใหญ่ที่สุดในโลก มันจะเบ่งบานทุกๆ 40 ปีเป็นเวลา 4 วัน!
ดอกบุกยักษ์ หรือ ดอกซากศพ (Amorphophallus Titanum) เป็นพืชในเขตป่าร้อนชื้น ในตระกูล ‘บัวผุด’ (Rafflesia) เป็นดอกไม้เดี่ยวที่มีขนาดใหญ่ที่สุด พบขึ้นอยู่บนเกาะสุมาตรา ประเทศอินโดนีเซียซึ่งจะบาน 72 ชั่วโมง และมีกลิ่นเหม็นคล้ายปลา เนื้อสัตว์เน่า หรือซากศพ ถูกค้นพบครั้งแรกเมื่อปี ค.ศ.1878 ทางหมู่เกาะสุมาตรา สูงโดยเฉลี่ยราว 1.6 เมตร
3 ตั๊กแตนหลากสี ที่มีสีที่แปลก และหายาก
ตั๊กแตนหลากสีพบได้ในมาดากัสการ์ เมื่อโตเต็มวัย จะมีขนาด 4 นิ้ว ซึ่งเป็นสัตว์ที่อันตรายมาก เพราะมันจะกินพืชที่มีพิษเพื่อป้องกันตัวจากอันตรายต่างๆดังนั้นหากมีสัตว์ที่จับตั๊กแตนหลากสีกินมันก็จะได้รับพิษเข้าไป
4 เชื้อราที่มีลักษณะเหมือนดอกไม้เมื่อดูจากกล้องจุลทรรศน์
6 นี่คือดอกไม้ที่เติบโตบนสถานีอวกาศ
ดอกไม้ที่ถูกเผยแพร่เป็นครั้งแร เป็นภาพของดอกบานชื่น (Zinnia) สีส้ม บานอยู่บนสถานีอวกาศ ซึ่งประกาศว่าเขาสามารถปลูกต้นไม้ได้บนอวกาศ และก่อนหน้านั้นได้ทดลองปลูกผักกาดหอมและผักสลัดร็อคเก็ตมาแล้ว
7 นี่เป็นภาพเอกซเรย์ (X-Ray) ของผู้ที่ทำท่าดัดร่างกายตัวเอง
8 นี่คือโครงกระดูกเม่น ที่คนส่วนมากไม่เคยเห็นมาก่อน
เม่น เป็นสัตว์ที่มีความเชื่อว่าสามารถสะบัดขนใส่ศัตรู แต่ความจริงไม่ใช่แบบนั้น เพราะเมื่อเม่นพบศัตรูจะรีบหันหลังแล้ววิ่งหนีไปพร้อมทั้งสั่นขนให้เกิดเสียงดังเพื่อเป็นการเตือนไม่ให้ศัตรูเข้าใกล้ แต่ถ้าศัตรูยังวิ่งไล่อยู่เม่นจะหยุดทันทีพร้อมทั้งพองขนให้ตั้งชันและวิ่งถอยหลัง หากศัตรูที่วิ่งตามไม่สามารถหยุดทันก็จะถูกขนเม่นทิ่มตำ
9 นักบินอวกาศพยายามพิสูจน์ว่าออกซิเจนสามารถเคลื่อนที่เข้าปอดมากน้อยแค่ไหน
10 และนี่คือเต่าทะเลเผือกทารกที่หายากอย่างไม่น่าเชื่อ
เต่าทะเลมีการวิวัฒนาการให้เหมาะสมกับสภาพแวดล้อมในทะเลและลดการแก่งแย่งกันเอง อย่างเช่น การกินอาหารที่แตกต่างกัน กระดองก็สามารถที่จะเปลี่ยนแปรได้ตามสิ่งแวดล้อม และในปัจจุบัน พบเต่าทะเลได้ในมหาสมุทรและทะเลทั่วโลก ยกเว้นมหาสมุทรใต้เท่านั้น
11 ใครจะเชื่อว่าเราสามารถวาดภาพได้ ด้วยแบคทีเรีย
12 นี่คือหน้าเต็มๆของมด ที่เราไม่เคยเห็นมาก่อน
13 และนี่อาจเป็นที่มาของ “How To Train Your Dragon”
14 ฟันของบีเว่อร์เป็นสีส้มเพราะมันมีธาตุเหล็ก และธาตุเหล็กนั้นทำให้ฟันแข็งแรงและสามารถแทะต้นไม้ได้อย่างดี
บีเวอร์ (beaver) เป็นสัตว์กินพืชเลี้ยงลูกด้วยนมจัดเป็นสัตว์ฟันแทะชนิดหนึ่งเช่นเดียวกับหนูยักษ์ บีเวอร์มีขนาดตัวที่ใหญ่ตัวโตเต็มวัยจะมีขนาดใหญ่พอ ๆ กับเด็กอายุ 8 ขวบ ตัวผู้มีน้ำหนักถึง 25 กิโลกรัมส่วนตัวเมียอาจมีขนาดใหญ่กว่าตัวผู้ นอกจากนี้บีเวอร์มีอายุยืนยาวถึง 24 ปี
15 ทากทะเลซึ่งมีลักษณะเหมือนใบไม้!
พวกมันสังเคราะห์แสงได้ ซึ่งเรียกกระบวนการนี้ว่า Kleptoplasty โดยจะมีการดูดซึมคลอโรพลาสต์ของสาหร่าย เพื่อใช้ในการสังเคราะห์แสงบนตัว เพื่อช่วยเติมพลังงานให้กับร่างกายของมัน พอมันโตขึ้น สีเขียวก็จะแผ่ไปตามขนาดร่างกาย
16 กบลูกดอกที่มีพิษ
กบลูกดอกพิษ (Poison Dart Frog) มีถิ่นที่อยู่แถบป่าฝนของทวีปอเมริกากลางมีพิษที่ร้ายแรงที่สุด เหมือนชุบปลายลูกศรเพื่อใช้เป็นอาวุธในการล่าสัตว์
18 Cynarina coral หรือ ปะการังตาแมว
19 ตุ๊กแกที่แก่ที่สุดในโลกมีอายุ 54 ล้านปี ซึ่งมันติดอยู่ในอำพัน
20 พวกงู ก็มีตัวเล็กๆจนเราอาจคิดว่าไส้เดือน
งูเส้นด้ายบาร์เบโดส (Barbados threadsnake) เป็นงูที่มีขนาดเล็กที่สุดในโลก พบในเกาะในแคริบเบียนของประเทศบาร์เบโดส และพบในเมืองอาบูเกีย (Abu Qir) ในประเทศอียิปต์
20 และนี่คือสิ่งที่ผิวของเสือดูเหมือนเมื่อมันถูกโกน

หนังของเสือก็มีลวดลายปรากฏตามที่เห็นบนขน เรียกได้ว่า โกนไปแล้ว เสือยังไม่ทิ้งลาย ยังคงความเป็นชาติพยัคฆ์ลายพาดกลอนเหมือนเดิม เพิ่มเติมคือเป็นหนังเกลี้ยงๆ
กัมพูชาเฮ! อ้าง พบแผนที่โบราณ 100 ปี ชี้หลายพื้นที่ชายแดนอาจอยู่ฝั่งกัมพูชา
รีวิว “Exterritorial พลิกแผนลับลวงระทึก” ภาพยนตร์สุดบู้ระห่ำต่อยกันหน้าแตกทั้งงเรื่อง!!
ไทยจะสงบเมื่อไหร่ หมด"ฮุน เซน" ก็ยังมี "สม รังสี"
ญี่ปุ่นเริ่มหนักใจแรงงานกัมพูชา หลังเกิดคดีขโมยโลหะครั้งใหญ่ – เสียงต้านแรงงานต่างด้าวเพิ่มขึ้นต่อเนื่อง
ราชกิจจาฯ เผยแพร่ คำสั่งศาลให้ นักแสดงรุ่นใหญ่ “มยุรฉัตร เหมือนประสิทธิเวช” ผู้จัดดัง เป็นคนไร้ความสามารถ
เสร็จสมบูรณ์แล้วญาญ่า บ้านเขาใหญ่ อลังการสวยงามตามากๆ
"นานา " ประกาศขายบ้านหรู 69 ล้านบาท กลางไอจี หลายฝ่ายมองว่ากำลังเตรียมเคลียร์ปัญหา หนี้สิน สินที่ติดค้างเพื่อน
“ย้อนวันวาน ‘ห้างเมโทร’ ปี 2512 – สัญลักษณ์ศูนย์การค้าโมเดิร์นยุคบุกเบิกแห่งเพชรบุรีตัดใหม่
ต้องตุนไว้เลย! 5 ผัก “เพนนิซิลินธรรมชาติ” เสริมภูมิคุ้มกันให้คนในบ้านช่วงอากาศเย็น
พม่าเปิดปฏิบัติการใหญ่! บดทำลายอุปกรณ์แก๊งคอลเซ็นเตอร์กลางเมืองชเวโก๊ะโก่
ส่อแววแตกหัก นานา เอาคืนอันฟอลพอลล่า เทอเลอร์ จับตาอันฟอล มีเพื่อนในแก๊ง เพิ่มหรือไม่
วิธีสังเกตภาพ AI ที่บางคนยังไม่รู้
พรรคประชาชน เปิดตัว แคนดิเดทนายกรัฐมนตรี ทั้ง 3 คน
นางงามจักรวาลที่สวมมงกุฎในแผ่นดินไทย เส้นทางแห่งความทรงจำของความงาม
มิสปาเลสไตน์แต่งงานแล้ว และ มีลูกกับลูกชายของ "มารวัน บาร์กูตี" ผู้ก่อการร้ายฟาตาห์
ญี่ปุ่นเริ่มหนักใจแรงงานกัมพูชา หลังเกิดคดีขโมยโลหะครั้งใหญ่ – เสียงต้านแรงงานต่างด้าวเพิ่มขึ้นต่อเนื่อง
ต้องตุนไว้เลย! 5 ผัก “เพนนิซิลินธรรมชาติ” เสริมภูมิคุ้มกันให้คนในบ้านช่วงอากาศเย็น
พม่าเปิดปฏิบัติการใหญ่! บดทำลายอุปกรณ์แก๊งคอลเซ็นเตอร์กลางเมืองชเวโก๊ะโก่
สถานการณ์น้ำท่วมร้านคาเฟ่ที่หาดใหญ่ ของ เคน ภูภูมิ" ตอนนี้น้ำสูงถึงระดับเอวแล้วเพื่อนๆส่งกำลังใจช่วย
ช็อควงการบันเทิง คู่รักต่างวัย ดีเจเพชรจ้า กับแฟนสาวรุ่นน้อง น้องเนปจูน เลือกเติบโตคนละเส้นทางเหลือไว้เพียงความทรงจำดีๆ
ส่อแววแตกหัก นานา เอาคืนอันฟอลพอลล่า เทอเลอร์ จับตาอันฟอล มีเพื่อนในแก๊ง เพิ่มหรือไม่
หัวหน้าพรรคเพื่อไทยตกใจ สิ่งที่หลุดออกมานั้นออกมาจากทางหัวหน้าพรรคประชาชนกรณี หารือและขอให้พรรคเพื่อไทยชะลอการยื่นอภิปรายไม่ไว้วางใจ ทั้งที่ขอให้เป็นความลับ